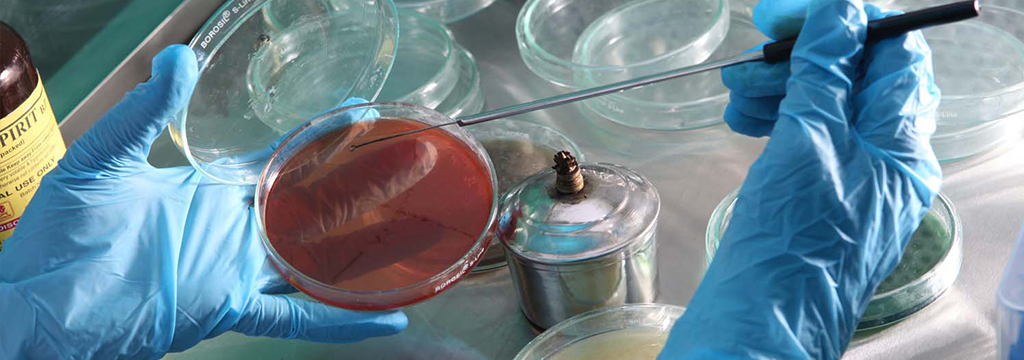

Quality Policy
To deliver to our consumers, seafood as close to the condition as it is found in, in its natural habitat a Fresh, Safe and Legal product by implementation of food safety and quality standards.
Royale Marine has incorporated appropriate procedures pertaining to quality assurance and quality control, which have been implemented so that safe and superior quality seafood is exported.
Royale marine has in-house laboratory to conduct special tests to detect the presence of micro organisms and anti-biotic to ensure the end product is absolutely contamination free.
Quality is monitored at every level and quality is maintained throughout the process right from shrimp’s farms till export of the finished product. Stringent quality measures are implemented at every stage
The system of traceability adopted by Royale Marine ensures tracking its products from hatchery to the consumer.
Royale marine's core strength lies in its well qualified, highly experienced and motivated team.
Royale Marine acknowledges that it is in compliance with Global standard for Food Safety Issue-6 and Food Safety System Certificate 22000, current Good Manufacturing Practices (GMP) 21 CFR Part110 of the United States Food and Drug Administration, Hazard Analysis Critical Control Point (HACCP) system based on Codex Alimentarius Commission’s guidelines, and other Codex standards, recommendations have been incorporated for consumer protection and to comply with the International food safety requirements.